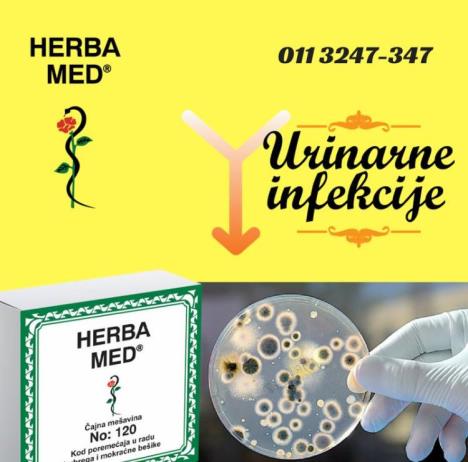
top-vesti-slika-18.jpg

Pratite poruke svog organizma, jer SIMPTOMI kao što su

-BOL U ŽELUCU, -NADIMANJE, -POJAČANO LUČENJE KISELINE, -GORUŠICA, - MUČNINA, -OSEĆAJ PECKANJA U PREDELU ŽELUCA, -NEKADA I GUBITAK APETITA, -NADUTOST STOMAKA I ZATVOR(OPSTIPACIJA ) ukazuju na neki od poremećaja organa za varenje,koji ako se ne otklone na vreme mogu da prerastu u GASTRITIS,ČIR NA ŽELUCU I DVANAESTOPALAČNOM CREVU,NERVOZA ŽELUCA I CREVA U IRITABILNI KOLON...itd..

Upravo su stomačne tegobe i najčešći zdravstveni problem,koje u velikoj meri narušavaju kvalitet svakodnevnog života,a pre svega treba utvrditi tačnu dijagnozu,kako bi se delovalo na uzrok,a ne na posledicu.

Savremen način života,neredovna ishrana,nervoza i stres često se ispoljavaju na sluznicu želuca i creva u vidu čira ili gastritisa,a tu je vrlo često prisutna i helikobacter pylori.
Pa,ako imate osećaj pečenja u gornjem delu stomaka,bola u želucu,gorušicu,mučninu,najbolje je da skuvate čaj u kojem ima slatkog korena,astragalusa,belog sleza jer sadrže sluzaste materije koje oblažu želudac i obnavljaju i regenrišu zaštitni sloj želuca i time ga štite.Kada se u sve ovo umešaju kantarion,hajd.trava,pelin i lincura,dobiju se odlični rezultati kod zaceljenja čira na želucu i dvanaest.crevu.

I upravo ove i još neke najdelotvornije biljke u odgovarajućem odnosu,kao sinergisti jedna drugoj,nalaze se u provereno dobroj kombinaciji čajne mešavine HERBA MED No: 36, koja na tržištu već 25 godine dokazuje da se svi ovi navedeni problemi digestivnog trakta mogu uspešno otkloniti,a zahvaljujući svojim antacidima pomaže i da se eliminiše dosadna i uporna helikobacter pylori,koja naseljava dublje slojeve sluznice želuca,stvara velike probleme i onemogućava normalno varenje.

Kao rezultat dugogodišnjeg ispitivanja i rada,imamo provereno efikasnu čajnu mešavinu HERBA MEDNo :36,čijom redovnom upotrebom tegobe nestanu brzo,ali treba nastaviti dok se problem potpuno ne reši. Česta pojava su i lenja creva i opstipacija,koja se takodje može lepo rešiti na potpuno prirodan način sa čajnom mešavinom HERBA MED No :209,koja NE SADRŽISENU i nije trenutni laksativ,već svojim aktivnim principom ubrzava peristaltiku creva i uspostavlja refleks pražnjenja.

Preporučujemo čajnu mešavinu HERBA MED No: 36 i No: 209,jer problemi sa stomakom i varenjem mogu biti prošlost.
U raznovrsnoj paleti proizvoda HERBA MED,ovoga puta ćemo da istaknemo izvanrednu čajnu mešavinu No:120,koja je odličan uroantiseptik,potpuno eliminiše bakterijske infekcije uro trakta,a zahvaljujući svojim jakim antiimflamantornim biljkama veoma brzo smiruje upalu mokraćne bešike i otklanja sve neprijatne simptome cistitisa,ali se naravno sa terapijom nastavlja do potpunog zdravog stanja uro trakta.Čajna mešavina No: 120 se preporučuje kao pomoć pri topljenju i eliminisanju peska i kamena u bubregu i bešici.
Sve informacije i porudžbine možete dobiti putem br.tel 011-3247-347 i 011-3286-195,
Apoteka HERBA MED
Skender begova 53 b,Beograd,
www.herbamed.co.rs
Čajne mešavine HERBA MED No:36, HERBA MED No: 209,HERBA MED No: 120 su odobrene od Ministarstva zdravlja Republike Srbije.
(Promo - tekst / Foto:Promo)